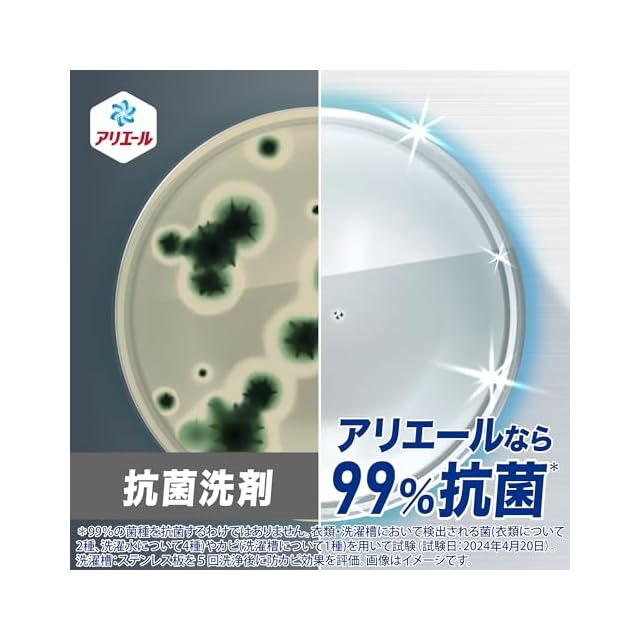

1/9
アリエール 洗濯洗剤 液体 超抗菌プレミアム 漂白剤級洗浄 清潔でさわやかな香り 詰め替え 625gx6袋 [ケース品]
¥2,827
International shipping available
【商品概要】
pattern:詰め替え 625g×6袋:
まるごと抗菌 衣類・洗濯水・洗濯槽 *全ての菌の増殖を抑えるわけではありません。
万能洗剤 1本で(1)洗濯槽防カビ、(2)つけ置きなしでも蓄積臭はがす、(3)せっけんなしでもシミ一発スッキリ *P&G調べ。ニオイの度合いで消臭の程度は異なります。汚れの度合いにより、汚れ落ちの程度は異なります。カビは除去できません。
シャツの汗臭、タオルの生乾き臭、加齢臭 - いろんなニオイを1本消臭 *P&G調べ。ニオイの度合いにより、落ち方の程度は異なります。
10%濃縮!同じ洗濯洗剤量で今までより+5枚洗える!*2023年アリエール超抗菌プレミアムシリーズ比。同じ洗濯水量設定の場合。
すすぎ1回OK!タテ・ドラム式対応。自動投入洗濯機にも。
梱包サイズ:88cm
-
レビュー
(64)
最近チェックした商品
その他の商品